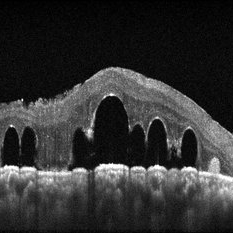
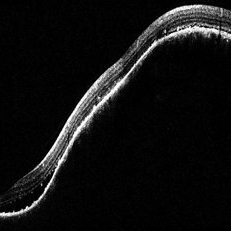
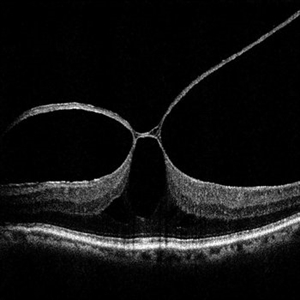

-
 Syphilis Neuroretinopathy
Syphilis Neuroretinopathy
Apr 2 2018 by JEFFERSON R SOUSA, Tecg.º (Biomedical Systems Technology)
Female patient, 21-years-old, with complaint of low vision in the right eye for 3 years. According to information from the patient's history, at the time she noticed the low vision, it also coincided with a picture of a strong urinary infection as well as episodes of constant tonsillitis. Yes, the patient did not seek medical attention and self-medicated with antibiotics. In ophthalmologic evaluation, as well as examinations of color retinography and ocular fundus autofluorescence, important pigmentary alterations were observed following vascular arches with pigment mobilization in osteoclasts (aspect of a unilateral pigmentary retinitis secondary to the inflammatory process). Which suggested inflammatory process sequelae. Through the laboratory tests, he had positive (+) confirmation for SYPHILIS NEURORETINOPATHY .
Photographer: JEFFERSON R SOUSA - Study Center and Ophthalmological Research Dr. Andre M V Gomes, Institute Dr. Suel Abujamra São Paulo-Brazil
Imaging device: Fundus camera Topcon TRC-50 DX, Imaginet 5.0, angle de 50 graus. Flash 100 / Mosaic with 10 images.
Condition/keywords: autofluorescence imaging, neurosyphilitic optic atrophy, retinitis pigmentosa, syphilis, syphilis neuroretinopathy
-
 Syphilis Neuroretinopathy
Syphilis Neuroretinopathy
Apr 2 2018 by JEFFERSON R SOUSA, Tecg.º (Biomedical Systems Technology)
Female patient, 21-years-old, with complaint of low vision in the right eye for 3 years. According to information from the patient's history, at the time she noticed the low vision, it also coincided with a picture of a strong urinary infection as well as episodes of constant tonsillitis. Yes, the patient did not seek medical attention and self-medicated with antibiotics. In ophthalmologic evaluation, as well as examinations of color retinography and ocular fundus autofluorescence, important pigmentary alterations were observed following vascular arches with pigment mobilization in osteoclasts (aspect of a unilateral pigmentary retinitis secondary to the inflammatory process). Which suggested inflammatory process sequelae. Through the laboratory tests, he had positive (+) confirmation for SYPHILIS NEURORETINOPATHY .
Photographer: JEFFERSON R SOUSA - Study Center and Ophthalmological Research Dr. Andre M V Gomes, Institute Dr. Suel Abujamra São Paulo-Brazil
Imaging device: Fundus camera Topcon TRC-50 DX, Imaginet 5.0, angle de 50 graus. Flash 36 / Mosaic with 10 images.
Condition/keywords: neurosyphilitic optic atrophy, retinitis pigmentosa, syphilis, syphilis neuroretinopathy
-
Hamartoma of the Retina
May 29 2018 by JEFFERSON R SOUSA, Tecg.º (Biomedical Systems Technology)
A 4-year-old male patient attended the clinic for evaluation. In the mapping examination and retina and retinography, important alterations were observed in the posterior pole of the left eye. This in turn was sent to perform the ocular ultrasonography examination, which together with the previous examinations, confirmed changes that suggested diagnosis of: COMBINED HAMARTOMA OF RETINA AND PIGMENTARY EPITHELIUM.
Photographer: JEFFERSON R SOUSA - Study Center and Ophthalmological Research Dr. Andre M V Gomes, Institute Dr. Suel Abujamra São Paulo-Brazil
Imaging device: Topcon TRC-50 DX, Imaginet 5.0, angle de 35º . Flash 36 / Mosaic with 9 images.
Condition/keywords: combined hamartoma, retinal pigment epithelium (RPE) hamartoma, tumor
-
Pterygium
Jul 4 2019 by JEFFERSON R SOUSA, Tecg.º (Biomedical Systems Technology)
A 45-year-old patient was admitted to the clinic with a diagnosis of diabetic retinopathy in which complementary examinations were requested, such as simple retinography and fluorescent retinography. In the follow-up evaluation, the presence of nasal pterygium was observed. In the previous follow-up angiography, it shows the vascularization.
Photographer: JEFFERSON R SOUSA - Study Center and Ophthalmological Research Dr. Andre M V Gomes, Institute Dr. Suel Abujamra São Paulo-Brazil
Imaging device: Topcon TRC-50 DX, Imaginet 5.0, angle de 35 graus. Flash 36
Condition/keywords: peripheral pterygium stationary
-
 Atrophic Pigment Epithelium
Atrophic Pigment Epithelium
Jul 19 2019 by JEFFERSON R SOUSA, Tecg.º (Biomedical Systems Technology)
Patient 16-years-old, visual acuity with light perception. In retinal evaluation presented total atrophy retinal pigment epithelium and total papilla excavation. Mobilization of pigments and presence of macular hemorrhage.
Photographer: JEFFERSON R SOUSA - Study Center and Ophthalmological Research Dr. Andre M V Gomes, Institute Dr. Suel Abujamra São Paulo-Brazil
Imaging device: Topcon TRC-50 DX, Imaginet 4.0, angle de 35 graus. Flash 12w-s
Condition/keywords: atrophic pigment epithelium
-
Serpiginous retinal degeneration
Jul 19 2019 by JEFFERSON R SOUSA, Tecg.º (Biomedical Systems Technology)
54-year-old female patient, visual acuity 20/100 both eyes. In the evaluation, she presented choroidal atrophy, starting from the optic nerve towards the periphery of the retina. Serpiginous retinal degeneration
Photographer: JEFFERSON R SOUSA - Study Center and Ophthalmological Research Dr. Andre M V Gomes, Institute Dr. Suel Abujamra São Paulo-Brazil
Imaging device: Topcon TRC-50 DX, Imaginet 4.0, angle de 35 graus. Flash 36 w-s
Condition/keywords: retinal degeneration, serpiginous
-
Serpiginous Retinal Degeneration
Jul 19 2019 by JEFFERSON R SOUSA, Tecg.º (Biomedical Systems Technology)
54-year-old female patient, visual acuity 20/100 both eyes. In the evaluation, she presented choroidal atrophy, starting from the optic nerve towards the periphery of the retina. Serpiginous retinal degeneration
Photographer: JEFFERSON R SOUSA - Study Center and Ophthalmological Research Dr. Andre M V Gomes, Institute Dr. Suel Abujamra São Paulo-Brazil
Imaging device: Topcon TRC-50 DX, Imaginet 4.0, angle de 35 graus. Flash 36 w-s
Condition/keywords: retinal degeneration, serpiginous
-
Uveitis Posterior
Jul 19 2019 by JEFFERSON R SOUSA, Tecg.º (Biomedical Systems Technology)
A 23-year-old male patient attended the clinic with low vision of the right eye. In the evaluation it presented important fundoscopical alterations like retinal exudations in the posterior pole and nasal retina, aspects of macular star. It was proven that it was a posterior uveitis.
Photographer: JEFFERSON R SOUSA - Study Center and Ophthalmological Research Dr. Andre M V Gomes, Institute Dr. Suel Abujamra São Paulo-Brazil
Imaging device: Topcon TRC-50 DX, Imaginet 4.0, angle de 50 graus. Flash 50w-s
Condition/keywords: uveitis
-
 dislocated crystalline lens
dislocated crystalline lens
Jul 25 2019 by JEFFERSON R SOUSA, Tecg.º (Biomedical Systems Technology)
Male patient 54-years-old. In the preoperative follow-up of cataract surgery, he suffered blunt trauma to the right eye, with a total dislocation of the lens.
Photographer: JEFFERSON R SOUSA - Study Center and Ophthalmological Research Dr. Andre M V Gomes, Institute Dr. Suel Abujamra São Paulo-Brazil
Imaging device: Topcon TRC-50 DX, Imaginet 5.0, angle de 50 graus. Flash 18W-S
Condition/keywords: dislocated crystalline lens
-
 Arterial Occlusion
Arterial Occlusion
Jul 25 2019 by JEFFERSON R SOUSA, Tecg.º (Biomedical Systems Technology)
Male patient 16-years-old, was admitted to the clinic with low vision failure. On evaluation, signs of arterial occlusion in the right eye were observed. The imaging exams in the clinical evaluation showed important changes in the blood flow of one of the carotid arteries (partial obstruction), probably atherosclerotic carotid disease.
Photographer: JEFFERSON R SOUSA - Study Center and Ophthalmological Research Dr. Andre M V Gomes, Institute Dr. Suel Abujamra São Paulo-Brazil
Imaging device: Topcon TRC-50 DX, Imaginet 5.0, angle de 50 graus. Flash 36
Condition/keywords: arterial occlusion
-
Dislocated Intraocular Lens (IOL)
Aug 2 2019 by JEFFERSON R SOUSA, Tecg.º (Biomedical Systems Technology)
A 53-year-old male patient suffered blunt trauma 15 days after cataract surgery. Note total dislocation of the intraocular lens. No glass reaction.
Photographer: JEFFERSON R SOUSA - Study Center and Ophthalmological Research Dr. Andre M V Gomes, Institute Dr. Suel Abujamra São Paulo-Brazil
Imaging device: Topcon TRC-50 DX, Imaginet 4.0, angle de 50 graus. Flash 18w-s
Condition/keywords: dislocated intraocular lens (IOL)
-
Gyrate Atrophy
Oct 30 2020 by JEFFERSON R SOUSA, Tecg.º (Biomedical Systems Technology)
Female patient, 28-year-old, with low vision in both eyes since childhood. In routine examination, important changes were observed with atrophic, symmetrical and bilateral aspects with apparently preservation of the central retina.
Condition/keywords: gyrate atrophy
-
Gyrate Atrophy
Oct 30 2020 by JEFFERSON R SOUSA, Tecg.º (Biomedical Systems Technology)
Female patient, 28-year-old, with low vision in both eyes since childhood. In routine examination, important changes were observed with atrophic, symmetrical and bilateral aspects with apparently preservation of the central retina.
Condition/keywords: gyrate atrophy
-
Gyrate Atrophy
Oct 30 2020 by JEFFERSON R SOUSA, Tecg.º (Biomedical Systems Technology)
Female patient, 28-year-old, with low vision in both eyes since childhood. In routine examination, important changes were observed with atrophic, symmetrical and bilateral aspects with apparently preservation of the central retina.
Condition/keywords: gyrate atrophy
-
Gyrate Atrophy
Oct 30 2020 by JEFFERSON R SOUSA, Tecg.º (Biomedical Systems Technology)
Female patient, 28-year-old, with low vision in both eyes since childhood. In routine examination, important changes were observed with atrophic, symmetrical and bilateral aspects with apparently preservation of the central retina.
Photographer: JEFFERSON R SOUSA - Study Center and Ophthalmological Research Dr. Andre M V Gomes, Institute Dr. Suel Abujamra São Paulo-Brazil
Imaging device: Topcon TRC-50 DX, Imaginet 5.0, angle de 50 graus. Flash 36 w-s
Condition/keywords: gyrate atrophy
-
 Retinoschisis
Retinoschisis
Mar 28 2021 by JEFFERSON R SOUSA, Tecg.º (Biomedical Systems Technology)
A 14-year-old male patient was admitted for visual assessment. Visual acuity without s / c in the right eye counts fingers and 20/80 in the left eye. According to family members, he reported low vision since childhood. He had previously been treated with photocoagulation at another service for which he had a diagnostic hypothesis of Coats' disease. Laboratory tests were requested (HIV, TOXO, TOXOCARIASIS, ECA, VDRL, PPD). In the evaluation, there was significant exudation in the posterior pole, some vascular irregularities in the right eye. In the left eye, there is a retinoschisis affecting the entire posterior pole and the nasal region to the optic disc, a macula with the characteristic aspect of a star. Well exemplified by OCT-A (Structure Deep: IPL - 25, OPL - 25).
Photographer: JEFFERSON R SOUSA - Study Center and Ophthalmological Research Dr. Andre M V Gomes, Institute Dr. Suel Abujamra São Paulo-Brazil
Imaging device: Optical Coherence Tomography system OCT CIRRUS 5000, Line Protocol, HD 21 line. Cirrus 5000 does not do a wide-angle tomographic image. This assembly was done manually with the junction of 11 lanes of 9mm each.
Condition/keywords: Coats' disease, retinoschisis
-
Coats' Disease
Mar 28 2021 by JEFFERSON R SOUSA, Tecg.º (Biomedical Systems Technology)
A 14-year-old male patient was admitted for visual evaluation. Visual acuity s/c in the right eye and 20/80 in the left eye. According to family members, he reported low vision since childhood. He had already undergone treatment with photocoagulation in another service to which he had a diagnostic hypothesis of Coatas disease. Laboratory tests were requested (HIV, TOXO, TOXOCARIASIS, ECA, VDRL, PPD). In the evaluation it was observed important exudation in the posterior pole, some vascular irregularities in the right eye. In the left eye, there is retinoschisis affecting the entire posterior pole and the region nasal to the optic disc, macula with a characteristic aspect of a cartwheel. Well exemplified by OCT-A (Structrure Deep: IPL - 25, OPL - 25).
Photographer: JEFFERSON R SOUSA - Study Center and Ophthalmological Research Dr. Andre M V Gomes, Institute Dr. Suel Abujamra São Paulo-Brazil
Imaging device: Topcon TRC-50 DX, Imaginet 4.0, angle de 50 graus. Flash 50w-s
Condition/keywords: Coats' disease, retinoschisis
-
 Retinoschisis
Retinoschisis
Mar 28 2021 by JEFFERSON R SOUSA, Tecg.º (Biomedical Systems Technology)
A 14-year-old male patient was admitted for visual evaluation. Visual acuity s/c in the right eye and 20/80 in the left eye. According to family members, he reported low vision since childhood. He had already undergone treatment with photocoagulation in another service to which he had a diagnostic hypothesis of Coats' disease. Laboratory tests were requested (HIV, TOXO, TOXOCARIASIS, ECA, VDRL, PPD). In the evaluation it was observed important exudation in the posterior pole, some vascular irregularities in the right eye. In the left eye, there is retinoschisis affecting the entire posterior pole and the region nasal to the optic disc, macula with a characteristic aspect of a cartwheel. Well exemplified by OCT-A (Structrure Deep: IPL - 25, OPL - 25).
Photographer: JEFFERSON R SOUSA - Study Center and Ophthalmological Research Dr. Andre M V Gomes, Institute Dr. Suel Abujamra São Paulo-Brazil
Imaging device: Topcon TRC-50 DX, Imaginet 4.0, angle de 50 graus. Flash 50w-s
Condition/keywords: Coats' disease, retinoschisis
-
 Retinoschisis
Retinoschisis
Mar 28 2021 by JEFFERSON R SOUSA, Tecg.º (Biomedical Systems Technology)
A 14-year-old male patient was admitted for visual assessment. Visual acuity s/c in the right eye and 20/80 in the left eye. According to family members, he reported low vision since childhood. He had already undergone photocoagulation treatment at another service for which he had a diagnostic hypothesis of Coats' disease. Laboratory tests were requested (HIV, TOXO, TOXOCARIASIS, ACE, VDRL, PPD). In the evaluation, there was significant exudation in the posterior pole, some vascular irregularities in the right eye. In the left eye, there is retinoschisis affecting the entire posterior pole and the nasal region to the optic disc, macula with a characteristic chariot-wheel appearance, well exemplified by OCT-A (Structrure Deep: IPL - 25, OPL - 25).
Photographer: JEFFERSON R SOUSA - Study Center and Ophthalmological Research Dr. Andre M V Gomes, Institute Dr. Suel Abujamra São Paulo-Brazil
Imaging device: Optical coherence tomography system Optical Coherence Tomography system OCT CIRRUS 5000, Line Protocol, HD 21 line. Cirrus 5000 does not do a wide-angle tomographic image. (Structrure Deep: IPL - 25, OPL - 25).
Condition/keywords: Coats' disease, retinoschisis
-
 Retinoschisis
Retinoschisis
Mar 28 2021 by JEFFERSON R SOUSA, Tecg.º (Biomedical Systems Technology)
A 14-year-old male patient was admitted for visual evaluation. Visual acuity s/c in the right eye and 20/80 in the left eye. According to family members, he reported low vision since childhood. He had already undergone treatment with photocoagulation in another service to which he had a diagnostic hypothesis of Coats' disease. Laboratory tests were requested (HIV, TOXO, TOXOCARIASIS, ECA, VDRL, PPD). In the evaluation it was observed important exudation in the posterior pole, some vascular irregularities in the right eye. In the left eye, there is retinoschisis affecting the entire posterior pole and the region nasal to the optic disc, macula with a characteristic aspect of a cartwheel. Well exemplified by OCT-A (Structrure Deep: IPL - 25, OPL - 25).
Photographer: JEFFERSON R SOUSA - Study Center and Ophthalmological Research Dr. Andre M V Gomes, Institute Dr. Suel Abujamra São Paulo-Brazil
Imaging device: Optical Coherence Tomography system OCT CIRRUS 5000, Line Protocol, HD 21 line. Cirrus 5000 does not do a wide-angle tomographic image. This assembly was done manually with the junction of 11 lanes of 9mm each.
Condition/keywords: Coats' disease, retinoschisis
-
 Diabetic Retinopathy
Diabetic Retinopathy
Aug 15 2021 by JEFFERSON R SOUSA, Tecg.º (Biomedical Systems Technology)
A 32-year-old female patient attended the Suel Abujamra Institute (ISA) for evaluation and management. In the process of evaluating the visual picture, important retinal alterations, typically of diabetic retinopathy, were observed. As shown in the OCT-A (Angioplex) exam, extensive area of ischemic vascular incompentence.
Photographer: JEFFERSON R SOUSA - Centro de Estudos e Pesquisas Oftalmológicas Dr. Andre MV Gomes, Instituto Dr. Suel Abujamra São Paulo-Brasil
Imaging device: Angioplex protocol, OCT CIRRUS 5000. Zeiss
Condition/keywords: diabetic mellitus, diabetic retinopathy, ischaemic diabetic maculopathy, ischemia, ocular ischemic syndrome, retinopathy
-
Ozurdex
Nov 9 2021 by JEFFERSON R SOUSA, Tecg.º (Biomedical Systems Technology)
In this image composition, two different photo planes were used, one with a normal sequence plane with focus on the retina and the other used the parameters of anterior tracking photography of the retinograph lens "A" with a compensation of 3 diopters to bring forward the focus of the image to Ozurdex stick. In order to fully visualize the medication, it is necessary to ask the patient to move his eyes up and down.
Photographer: JEFFERSON R SOUSA - Study Center and Ophthalmological Research Dr. Andre M V Gomes, Institute Dr. Suel Abujamra São Paulo-Brazil
Imaging device: Topcon TRC-50 DX, Imaginet 5.0, angle de 50 graus. Flash 50 / Mosaic with 10 images.
Condition/keywords: ozurdex, Ozurdex implant, UZUR, uzurde, UZURDEX INJECTION
-
 Tapetoretinal Degeneration
Tapetoretinal Degeneration
Sep 7 2022 by JEFFERSON R SOUSA, Tecg.º (Biomedical Systems Technology)
Patient 52 years old, Male, progressive loss of vision since the age of 20. Retinography showed mobilization of pigments in osteoblasts, extensive area of atrophy of the pigmentary epithelium and choroid. On fluorescein angiography, typical changes following the characteristic patterns of paracentra retinal retinitis pigmentosa. Autofluorescent fundus with a sectorial autohypofluorescence pattern in the regions of atrophies.
Photographer: JEFFERSON ROCHA DE SOUSA - Retinal Department at Instituto Dr. Suel Abujamra Sao Paulo-Brazil
Imaging device: Clarus 700 - Zeiss, composite of four 135 degree images.
Condition/keywords: pericentral retinitis pigmentosa, tapeoretinal degeneration
-
 Tapetoretinal Degeneration
Tapetoretinal Degeneration
Sep 7 2022 by JEFFERSON R SOUSA, Tecg.º (Biomedical Systems Technology)
Patient 52 years old, Male, progressive loss of vision since the age of 20. Retinography showed mobilization of pigments in osteoblasts, extensive area of atrophy of the pigmentary epithelium and choroid. On fluorescein angiography, typical changes following the characteristic patterns of paracentra retinal retinitis pigmentosa. Autofluorescent fundus with a sectorial autohypofluorescence pattern in the regions of atrophies.
Photographer: JEFFERSON ROCHA DE SOUSA - Retinal Department at Instituto Dr. Suel Abujamra Sao Paulo-Brazil
Imaging device: Clarus 700 - Zeiss, composite of four 135 degree images.
Condition/keywords: pericentral retinitis pigmentosa, tapeoretinal degeneration
-
 Tapetoretinal Degeneration
Tapetoretinal Degeneration
Sep 7 2022 by JEFFERSON R SOUSA, Tecg.º (Biomedical Systems Technology)
Patient 52 years old, Male, progressive loss of vision since the age of 20. Retinography showed mobilization of pigments in osteoblasts, extensive area of atrophy of the pigmentary epithelium and choroid. On fluorescein angiography, typical changes following the characteristic patterns of paracentra retinal retinitis pigmentosa. Autofluorescent fundus with a sectorial autohypofluorescence pattern in the regions of atrophies.
Photographer: JEFFERSON ROCHA DE SOUSA - Retinal Department at Instituto Dr. Suel Abujamra Sao Paulo-Brazil
Imaging device: Clarus 700 - Zeiss, composite of four 135 degree images.
Condition/keywords: pericentral retinitis pigmentosa, tapeoretinal degeneration
-
 Tapetoretinal Degeneration
Tapetoretinal Degeneration
Sep 7 2022 by JEFFERSON R SOUSA, Tecg.º (Biomedical Systems Technology)
Patient 52 years old, Male, progressive loss of vision since the age of 20. Retinography showed mobilization of pigments in osteoblasts, extensive area of atrophy of the pigmentary epithelium and choroid. On fluorescein angiography, typical changes following the characteristic patterns of paracentra retinal retinitis pigmentosa. Autofluorescent fundus with a sectorial autohypofluorescence pattern in the regions of atrophies.
Photographer: JEFFERSON ROCHA DE SOUSA - Retinal Department at Instituto Dr. Suel Abujamra Sao Paulo-Brazil
Imaging device: Clarus 700 - Zeiss, composite of four 135 degree images.
Condition/keywords: pericentral retinitis pigmentosa, tapeoretinal degeneration
-
 submacular perfluorocarbon liquid
submacular perfluorocarbon liquid
Sep 7 2022 by JEFFERSON R SOUSA, Tecg.º (Biomedical Systems Technology)
A 63-year-old male patient underwent vitreoretinal surgery with the use of perfluorocarbon. From a technological point of view, extended-field retinography presents many points of focus variation due to the difficulty of establishing a diffuse focus, as it is a recent post-operative case. In OCT Fundus Enface, although it has a low resolution, it is extremely important for documenting the presence of perfluor. Best seen in structural OCT.
Photographer: JEFFERSON ROCHA DE SOUSA - Retinal Department at Instituto Dr. Suel Abujamra Sao Paulo-Brazil
Imaging device: Optical Coherence Tomography system OCT CIRRUS 5000, Protocol OCT Fundus Enface.
Condition/keywords: perfluorocarbon fluid, post-vitrectomy, submacular perfluorocarbon liquid (PFO), vitrectomy
-
submacular perfluorocarbon liquid
submacular perfluorocarbon liquid
Sep 7 2022 by JEFFERSON R SOUSA, Tecg.º (Biomedical Systems Technology)
A 63-year-old male patient underwent vitreoretinal surgery with the use of perfluorocarbon. From a technological point of view, extended-field retinography presents many points of focus variation due to the difficulty of establishing a diffuse focus, as it is a recent post-operative case. In OCT Fundus Enface, although it has a low resolution, it is extremely important for documenting the presence of perfluor. Best seen in structural OCT.
Photographer: JEFFERSON ROCHA DE SOUSA - Retinal Department at Instituto Dr. Suel Abujamra Sao Paulo-Brazil
Imaging device: Optical Coherence Tomography system OCT CIRRUS 5000, Protocol, HD 5 Line
Condition/keywords: perfluorocarbon fluid, post-vitrectomy, submacular perfluorocarbon liquid (PFO), vitrectomy
-
 submacular perfluorocarbon liquid
submacular perfluorocarbon liquid
Sep 7 2022 by JEFFERSON R SOUSA, Tecg.º (Biomedical Systems Technology)
A 63-year-old male patient underwent vitreoretinal surgery with the use of perfluorocarbon. From a technological point of view, extended-field retinography presents many points of focus variation due to the difficulty of establishing a diffuse focus, as it is a recent post-operative case. In OCT Fundus Enface, although it has a low resolution, it is extremely important for documenting the presence of perfluor. Best seen in structural OCT.
Photographer: JEFFERSON ROCHA DE SOUSA - Retinal Department at Instituto Dr. Suel Abujamra Sao Paulo-Brazil
Imaging device: Clarus 700 - Zeiss, 135 degree images.
Condition/keywords: perfluorocarbon fluid, post-vitrectomy, submacular perfluorocarbon liquid (PFO), vitrectomy
-
 Choroid hemangioma
Choroid hemangioma
Sep 7 2022 by JEFFERSON R SOUSA, Tecg.º (Biomedical Systems Technology)
Patient 54 years old, Female, progressive loss of vision. In the multimodal evaluation of the retina showed important retinal alterations. A discreet opacity of the media impairs the quality of the images. In the Autofluorescent Background Image with a green filter, because it reaches a depth in the retinal tissue, it is able to show changes that affect the retinal pigment epithelium, it was better in this case than with the green filter. WF retinography shows an elevated, slightly reddish lesion, probable serous retinal detachment, mobilization of pigments and phantom vessels.
Photographer: JEFFERSON ROCHA DE SOUSA - Retinal Department at Instituto Dr. Suel Abujamra Sao Paulo-Brazil
Imaging device: Clarus 700 - Zeiss 135 degree images. Multimodal Evaluation
Condition/keywords: elevated retinal lesion, hemangioma, melanoma, serous retinal detachment
-
 Choroid hemangioma
Choroid hemangioma
Sep 7 2022 by JEFFERSON R SOUSA, Tecg.º (Biomedical Systems Technology)
Patient 54 years old, Female, progressive loss of vision. In the multimodal evaluation of the retina showed important retinal alterations. A discreet opacity of the media impairs the quality of the images. In the Autofluorescent Background Image with a green filter, because it reaches a depth in the retinal tissue, it is able to show changes that affect the retinal pigment epithelium, it was better in this case than with the green filter. WF retinography shows an elevated, slightly reddish lesion, probable serous retinal detachment, mobilization of pigments and phantom vessels.
Photographer: JEFFERSON ROCHA DE SOUSA - Retinal Department at Instituto Dr. Suel Abujamra Sao Paulo-Brazil
Imaging device: Clarus 700 - Zeiss 135 degree images. Multimodal Evaluation
Condition/keywords: elevated retinal lesion, hemangioma, melanoma, serous retinal detachment
-
 Luxated lens to anterior segment
Luxated lens to anterior segment
Sep 7 2022 by JEFFERSON R SOUSA, Tecg.º (Biomedical Systems Technology)
Patient 61 years old, Female, subta low vision after blunt trauma. In the anterior segment photograph, the presence of a lens in the anterior chamber is observed. In the previous follow-up OCT, the disorganization of this follow-up is clear. Above all, the documentation of these cases is essential for future decisions. This patient was urgently referred for a surgical procedure, mainly to control the intraocular pressure, which was at 60 IOP.
Photographer: JEFFERSON ROCHA DE SOUSA - Retinal Department at Instituto Dr. Suel Abujamra Sao Paulo-Brazil.
Imaging device: Optical Coherence Tomography System - OCT CIRRUS 5000, Protocol Wide Angle to Angle.
Condition/keywords: lens luxation, Luxated lens to anterior segment, subluxation of lens
-
 Luxated lens to anterior segment
Luxated lens to anterior segment
Sep 7 2022 by JEFFERSON R SOUSA, Tecg.º (Biomedical Systems Technology)
Patient 61 years old, Female, subta low vision after blunt trauma. In the anterior segment photograph, the presence of a lens in the anterior chamber is observed. In the previous follow-up OCT, the disorganization of this follow-up is clear. Above all, the documentation of these cases is essential for future decisions. This patient was urgently referred for a surgical procedure, mainly to control the intraocular pressure, which was at 60 IOP.
Photographer: JEFFERSON ROCHA DE SOUSA - Retinal Department at Instituto Dr. Suel Abujamra Sao Paulo-Brazil.
Imaging device: Clarus 700 - Zeiss,
Condition/keywords: lens luxation, Luxated lens to anterior segment, subluxation of lens
-
 Luxated lens to anterior segment
Luxated lens to anterior segment
Sep 7 2022 by JEFFERSON R SOUSA, Tecg.º (Biomedical Systems Technology)
Patient 61 years old, Female, subta low vision after blunt trauma. In the anterior segment photograph, the presence of a lens in the anterior chamber is observed. In the previous follow-up OCT, the disorganization of this follow-up is clear. Above all, the documentation of these cases is essential for future decisions. This patient was urgently referred for a surgical procedure, mainly to control the intraocular pressure, which was at 60 IOP.
Photographer: JEFFERSON ROCHA DE SOUSA - Retinal Department at Instituto Dr. Suel Abujamra Sao Paulo-Brazil.
Imaging device: Optical Coherence Tomography System - OCT CIRRUS 5000, Protocol Wide Angle to Angle.
Condition/keywords: lens luxation, LUX, Luxated lens to anterior segment, subluxation of lens
-
 RETINOSCHISIS
RETINOSCHISIS
Sep 7 2022 by JEFFERSON R SOUSA, Tecg.º (Biomedical Systems Technology)
Patient 55 years old, Female, progressive loss of vision. In funduscopic evaluation and photographic documentation, the presence of retinoschisis in the inferior temporal region surrounded with laser photocoagulation was observed.
Photographer: JEFFERSON ROCHA DE SOUSA - Departamento de Retina do Instituto Dr. Suel Abujamra São Paulo-Brasil.
Imaging device: Clarus 700 - Zeiss, 135-degree images.
Condition/keywords: fold in outer layer of retinoschisis, retinoschisis
-
 Retinal detachment, Coloboma
Retinal detachment, Coloboma
Oct 17 2022 by JEFFERSON R SOUSA, Tecg.º (Biomedical Systems Technology)
Male patient, 58 years old, PIO 19-21, AV; OD 20/200, OS 20/20. He had sudden low vision, with progressive worsening in his right eye. He underwent evaluation in retinal mapping and further examinations where important funduscopic changes were found. Both eyes had an atrophic lesion suggestive of coloboma of the retina in the lower arch. Right eye with retinal detachment with macular involvement.
Photographer: JEFFERSON ROCHA DE SOUSA - Retinal Department at Instituto Dr. Suel Abujamra Sao Paulo-Brazil
Imaging device: Clarus 700 - Zeiss, composite of four 135 degree images.
Condition/keywords: coloboma, coloboma of choroid, Retinal Detachment
-
 Retinal detachment
Retinal detachment
Oct 17 2022 by JEFFERSON R SOUSA, Tecg.º (Biomedical Systems Technology)
Male patient, 58 years old, PIO; 19-21, AV; OD 20/200, OS 20/20. He had sudden low vision, with progressive worsening in his right eye. He underwent evaluation in retinal mapping and further examinations where important funduscopic changes were found. Both eyes had an atrophic lesion suggestive of coloboma of the retina in the lower arch. Right eye with retinal detachment with macular involvement.
Photographer: JEFFERSON ROCHA DE SOUSA - Retinal Department at Instituto Dr. Suel Abujamra Sao Paulo-Brazil
Imaging device: Clarus 700 - Zeiss, composite of four 135 degree images.
Condition/keywords: coloboma, coloboma of choroid, Retinal Detachment
-
 Retinal detachment, Coloboma
Retinal detachment, Coloboma
Oct 17 2022 by JEFFERSON R SOUSA, Tecg.º (Biomedical Systems Technology)
Male patient, 58 years old, PIO; 19-21, AV; OD 20/200, OS 20/20. He had sudden low vision, with progressive worsening in his right eye. He underwent evaluation in retinal mapping and further examinations where important funduscopic changes were found. Both eyes had an atrophic lesion suggestive of coloboma of the retina in the lower arch. Right eye with retinal detachment with macular involvement.
Photographer: JEFFERSON ROCHA DE SOUSA - Retinal Department at Instituto Dr. Suel Abujamra Sao Paulo-Brazil
Imaging device: Clarus 700 - Zeiss, composite of four 135 degree images. CIRRUS 5000, Protocol, HD 5 Line. con
Condition/keywords: coloboma of choroid, Retinal Detachment
-
 Coats Disease
Coats Disease
May 2 2023 by JEFFERSON R SOUSA, Tecg.º (Biomedical Systems Technology)
Male patient, 7 years old, with low acuity. The patient's difficulty seeing was noticed in a school eye care project. In the screening exam, the child's difficulty seeing was evident. In the specialty exams, important retinal alterations suggestive of Coats Disease were noted.
Photographer: JEFFERSON ROCHA DE SOUSA - Department of Retina at Institute Suel Abujamra - ISA, São Paulo - Brazil.
Imaging device: Clarus 700 - Zeiss.
Condition/keywords: Coats disease
-
 Birdshot Retinopathy
Birdshot Retinopathy
May 9 2023 by JEFFERSON R SOUSA, Tecg.º (Biomedical Systems Technology)
Female patient, 41 years old, with progressive low visual acuity, progressive history of autoimmune disease. In the multimodal retinal fundoscopic evaluation, important characteristics compatible with "Birdshot Retinopathy" were observed. Birdshot retinopathy, also known as birdshot chorioretinopathy or birdshot uveitis, is a rare, chronic inflammatory disorder that affects the retina and the choroid of the eye. It typically develops in adults between the ages of 30 and 60 years, and is more common in women than men. The name "birdshot" refers to the small, round, yellow-white spots that appear on the retina, which resemble the pattern of a shotgun blast. These spots are caused by inflammation in the eye, and can lead to vision loss if left untreated. Symptoms of birdshot retinopathy include blurred vision, floaters, loss of night vision, and difficulty adapting to changes in lighting. The condition can also cause inflammation in other parts of the eye, leading to redness, pain, and sensitivity to light. The exact cause of birdshot retinopathy is unknown, but it is believed to be an autoimmune disorder, in which the body's immune system mistakenly attacks the retina and choroid. Treatment typically involves the use of immunosuppressive medications, such as corticosteroids or biologic agents, to reduce inflammation and preserve vision. Close monitoring by an ophthalmologist is important, as the disease can progress even with.
Photographer: JEFFERSON ROCHA DE SOUSA - Retinal Department at Institute Dr. Suel Abujamra Sao Paulo-Brazil
Imaging device: Clarus 700 - Zeiss, composition of five 135 degree images.
Condition/keywords: bilateral chorioretinal folds, birdshot, birdshot chorioretinopathy, birdshot choroidopathy, birdshot retinochoroidopathy
-
 Birdshot Retinopathy
Birdshot Retinopathy
May 9 2023 by JEFFERSON R SOUSA, Tecg.º (Biomedical Systems Technology)
Female patient, 41 years old, with progressive low visual acuity, progressive history of autoimmune disease. In the multimodal retinal fundoscopic evaluation, important characteristics compatible with "Birdshot Retinopathy" were observed. Birdshot retinopathy, also known as birdshot chorioretinopathy or birdshot uveitis, is a rare, chronic inflammatory disorder that affects the retina and the choroid of the eye. It typically develops in adults between the ages of 30 and 60 years, and is more common in women than men. The name "birdshot" refers to the small, round, yellow-white spots that appear on the retina, which resemble the pattern of a shotgun blast. These spots are caused by inflammation in the eye, and can lead to vision loss if left untreated. Symptoms of birdshot retinopathy include blurred vision, floaters, loss of night vision, and difficulty adapting to changes in lighting. The condition can also cause inflammation in other parts of the eye, leading to redness, pain, and sensitivity to light. The exact cause of birdshot retinopathy is unknown, but it is believed to be an autoimmune disorder, in which the body's immune system mistakenly attacks the retina and choroid. Treatment typically involves the use of immunosuppressive medications, such as corticosteroids or biologic agents, to reduce inflammation and preserve vision. Close monitoring by an ophthalmologist is important, as the disease can progress even with.
Photographer: JEFFERSON ROCHA DE SOUSA - Retinal Department at Institute Dr. Suel Abujamra Sao Paulo-Brazil
Imaging device: Clarus 700 - Zeiss, composite of four 135 degree images.
Condition/keywords: bilateral chorioretinal folds, birdshot, birdshot chorioretinopathy, birdshot choroidopathy, birdshot retinochoroidopathy
-
 Retinal Astrocytoma
Retinal Astrocytoma
May 9 2023 by JEFFERSON R SOUSA, Tecg.º (Biomedical Systems Technology)
Retinal astrocytoma, also known as astrocytic hamartoma, is a rare benign tumor that occurs in the retina of the eye. It is a type of hamartoma, which means that it is made up of normal tissue that is growing in an abnormal way. Retinal astrocytomas are typically found in children and young adults and may be associated with a genetic condition called tuberous sclerosis complex. They can cause vision problems such as decreased visual acuity, visual field defects, and retinal detachment.
Photographer: JEFFERSON ROCHA DE SOUSA - Retinal Department at Institute Dr. Suel Abujamra Sao Paulo-Brazil
Imaging device: Clarus 700 - Zeiss, 135 degree images end CIRRUS 5000, Protocol, HD 5 Line
Condition/keywords: astrocytic hamartoma, astrocytoma
-
 Diabetic Retinopathy
Diabetic Retinopathy
Aug 19 2025 by JEFFERSON R SOUSA, Tecg.º (Biomedical Systems Technology)
Female patient, 74 years old, with a history of severe photocoagulated diabetic retinopathy in both eyes.
Photographer: JEFFERSON ROCHA DE SOUSA - Retinal Department at Lens Oftalmologia, Sao Paulo-Brazil
Imaging device: EIDON fundus camera with a 110° field of view, confocal scanning technology. Widefield co-op with 4 images.
Condition/keywords: background diabetic retinopathy (BDR), Diabetic Retinopathy
-
 Diabetic Retinopathy
Diabetic Retinopathy
Aug 19 2025 by JEFFERSON R SOUSA, Tecg.º (Biomedical Systems Technology)
Female patient, 74 years old, with a history of severe photocoagulated diabetic retinopathy in both eyes.
Photographer: JEFFERSON ROCHA DE SOUSA - Retinal Department at Lens Oftalmologia, Sao Paulo-Brazil
Imaging device: EIDON fundus camera with a 110° field of view, confocal scanning technology. Widefield co-op with 6 images.
Condition/keywords: background diabetic retinopathy (BDR), Diabetic Retinopathy
-
 Choroidal Melanoma
Choroidal Melanoma
Aug 19 2025 by JEFFERSON R SOUSA, Tecg.º (Biomedical Systems Technology)
A 54-year-old woman with progressive visual acuity loss in her left eye was admitted to the institution with a significant elevated lesion in the upper arch with macular involvement, confirmed by wide-angle fundus photography, ultrasound, and optical coherence tomography.
Photographer: JEFFERSON ROCHA DE SOUSA - Retinal Department at Lens Oftalmologia, Sao Paulo-Brazil
Imaging device: Clarus 700 - Zeiss, composite of four 135 degree images.
Condition/keywords: melanoma
-
 silicone oil
silicone oil
Mar 29 2018 by JEFFERSON R SOUSA, Tecg.º (Biomedical Systems Technology)
Female patient, 56-years-old, with presence of silicone oil in anterior chamber.
Photographer: JEFFERSON R SOUSA - Study Center and Ophthalmological Research Dr. Andre M V Gomes, Institute Dr. Suel Abujamra São Paulo-Brazil
Imaging device: Topcon TRC-50 DX, Imaginet 5.0, angle de 20 graus. Flash 50.
Condition/keywords: peri-silicon oil deposits, silicone drop space of martegiani, silicone oil
-
 Drusen
Drusen
Mar 29 2018 by JEFFERSON R SOUSA, Tecg.º (Biomedical Systems Technology)
Male patient 27-years-old, with complaint of low vision in both eyes. The fundoscopic evaluationfound the presence of drusen topography in the posterior pole with foveal. Fluorescein angiography shows the typical pattern of hyperfluorescence of drusen in the first minute of angiography.
Photographer: JEFFERSON R SOUSA - Study Center and Ophthalmological Research Dr. Andre M V Gomes, Institute Dr. Suel Abujamra São Paulo-Brazil
Imaging device: Topcon TRC-50 DX, Imaginet 5.0, angle de 50 graus. Flash 150.
Condition/keywords: colloidal drusen, drusen
-
 Drusen
Drusen
Mar 29 2018 by JEFFERSON R SOUSA, Tecg.º (Biomedical Systems Technology)
Male patient 27-years-old, with complaint of low vision in both eyes. The fundoscopic evaluation found the presence of drusen topography in the posterior pole with foveal. Fluorescein angiography shows the typical pattern of hyperfluorescence of drusen in the first minute of angiography.
Photographer: JEFFERSON R SOUSA - Study Center and Ophthalmological Research Dr. Andre M V Gomes, Institute Dr. Suel Abujamra São Paulo-Brazil
Imaging device: Topcon TRC-50 DX, Imaginet 5.0, angle de 50 graus. Flash 150.
Condition/keywords: colloidal drusen, drusen
-
 Drusen
Drusen
Mar 29 2018 by JEFFERSON R SOUSA, Tecg.º (Biomedical Systems Technology)
Male patient, 27-years-old, with complaint of low vision in both eyes. The fundoscopic evaluation was found the presence of drusen topography in the posterior pole with foveal. Fluorescein angiography shows the typical pattern of hyperfluorescence of drusen in the first minute of angiography.
Photographer: JEFFERSON R SOUSA - Study Center and Ophthalmological Research Dr. Andre M V Gomes, Institute Dr. Suel Abujamra São Paulo-Brazil
Imaging device: Topcon TRC-50 DX, Imaginet 5.0, angle de 20 graus. Flash 150.
Condition/keywords: colloidal drusen, drusen
-
 Drusen
Drusen
Mar 29 2018 by JEFFERSON R SOUSA, Tecg.º (Biomedical Systems Technology)
Male patient 27-years-old, with complaint of low vision in both eyes. The fundoscopic evaluation found the presence of drusen topography in the posterior pole with foveal. Fluorescein angiography shows the typical pattern of hyperfluorescence of drusen in the first minute of angiography.
Photographer: JEFFERSON R SOUSA - Study Center and Ophthalmological Research Dr. Andre M V Gomes, Institute Dr. Suel Abujamra São Paulo-Brazil
Imaging device: Topcon TRC-50 DX, Imaginet 5.0, angle de 20 graus. Flash 150.
Condition/keywords: colloidal drusen, drusen
-
 Drusen of Optic Disc
Drusen of Optic Disc
Mar 6 2018 by JEFFERSON R SOUSA, Tecg.º (Biomedical Systems Technology)
Female patient, 37 years old, Caucasian, with complaint of low lateral stroke in abos the eyes. In the retinal mapping examination and retinography, important alterations in the optic nerve head suggestive of DRUSAS DE PAPILA were observed. After being confirmed in the Autofluorescence examination, we observed Autohyperfluorescence compatible with deposits of calcified hyaline material, as well as another complementary exam such as USG and OCT.
Photographer: JEFFERSON R SOUSA - Study Center and Ophthalmological Research Dr. Andre M V Gomes, Institute Dr. Suel Abujamra, Clinic Marco Antonio Albhy Ophthalmology / São Paulo-Brazil
Imaging device: Heidelberg - HRA Angiograph, Autofluorescence com 30 degrees.
Condition/keywords: calcified drusen, drusen of optic disc
-
 Drusen of Optic Disc
Drusen of Optic Disc
Mar 6 2018 by JEFFERSON R SOUSA, Tecg.º (Biomedical Systems Technology)
Female patient, 37 years old, Caucasian, with complaint of low lateral stroke in abos the eyes. In the retinal mapping examination and retinography, important alterations in the optic nerve head suggestive of Drusen PAPILLA were observed. After being confirmed in the Autofluorescence examination, we observed Autohyperfluorescence compatible with deposits of calcified hyaline material, as well as another complementary exam such as USG and OCT.
Photographer: JEFFERSON R SOUSA - Study Center and Ophthalmological Research Dr. Andre M V Gomes, Institute Dr. Suel Abujamra, Clinic Marco Antonio Albhy Ophthalmology, São Paulo-Brazil
Imaging device: Heidelberg - HRA Angiograph, Autofluorescence com 30 degrees.
Condition/keywords: calcified drusen, drusen of optic disc
-
 occlusion of retinal vein
occlusion of retinal vein
Mar 15 2018 by JEFFERSON R SOUSA, Tecg.º (Biomedical Systems Technology)
Male patient, 55 years old, with low vision in the right eye. In the retinal mapping examination and color photography, important alterations were observed suggesting an occlusion of the inferior vein. It was later confirmed in fluorescein angiography.
Photographer: JEFFERSON R SOUSA - Study Center and Ophthalmological Research Dr. Andre M V Gomes, Institute Dr. Suel Abujamra São Paulo-Brazil
Imaging device: Heidelberg Engineering HRA - 2 or Spectralis Angiograph, 30 degrees.
Condition/keywords: occlusion of retinal vein, oclus
-
 Cataract
Cataract
Feb 24 2018 by JEFFERSON R SOUSA, Tecg.º (Biomedical Systems Technology)
81-year-old patient, male, in surgical procedure (Facectomy - FEC). Removal of the fully opacified lens is observed.
Photographer: JEFFERSON R SOUSA - Study Center and Ophthalmological Research Dr. Andre M V Gomes, Institute Dr. Suel Abujamra São Paulo-Brazil
Imaging device: Canon / Lens Sigma 35mm F / 1.4 Dg Hsm. without flash user and keeping the limits of safety of the surgeon.
Condition/keywords: cataract surgery
-
 Pseudoexfoliation
Pseudoexfoliation
Feb 24 2018 by JEFFERSON R SOUSA, Tecg.º (Biomedical Systems Technology)
53-year-old patient, male, AV 20/60. It has a central pseudoexfoliation. Certainly you will have indication of cataract surgery.
Photographer: JEFFERSON R SOUSA - Study Center and Ophthalmological Research Dr. Andre M V Gomes, Institute Dr. Suel Abujamra São Paulo-Brazil
Condition/keywords: crystalline lens, crystals, pseudoexfoliation glaucoma, pseudoexfoliation of lens capsule, pseudoexfoliation syndrome
-
Crystalline Luxation
Feb 23 2018 by JEFFERSON R SOUSA, Tecg.º (Biomedical Systems Technology)
40-year-old patient, with displaced lens (dislocated), after suffering blunt trauma.
Photographer: JEFFERSON R SOUSA - Study Center and Ophthalmological Research Dr. Andre M V Gomes, Institute Dr. Suel Abujamra São Paulo-Brazil
Imaging device: Topcon TRC-50 DX, Imaginet 5.0, angle de 20 graus. Flash 50.
Condition/keywords: dislocated crystalline lens
-
 CORNEA
CORNEA
Feb 23 2018 by JEFFERSON R SOUSA, Tecg.º (Biomedical Systems Technology)
64-year-old patient, with vision loss more than 10 years after having suffered blunt trauma with ocular perforation.
Photographer: JEFFERSON R SOUSA - Study Center and Ophthalmological Research Dr. Andre M V Gomes, Institute Dr. Suel Abujamra São Paulo-Brazil
Imaging device: Topcon TRC-50 DX, Imaginet 5.0, angle de 20 graus. Flash 36.
Condition/keywords: 20 degrees, central opacity of cornea, corneal edema, neovascularization (NV)
-
 Cornea
Cornea
Feb 23 2018 by JEFFERSON R SOUSA, Tecg.º (Biomedical Systems Technology)
64-year-old, patient with vision loss more than 10 years after having suffered blunt trauma with ocular perforation.
Photographer: JEFFERSON R SOUSA - Study Center and Ophthalmological Research Dr. Andre M V Gomes, Institute Dr. Suel Abujamra São Paulo-Brazil
Imaging device: Topcon TRC-50 DX, Imaginet 5.0, angle de 20 graus. Flash 36.
Condition/keywords: 20 degrees, central opacity of cornea, corneal edema, neovascularization (NV)
-
 choroidal hemangioma
choroidal hemangioma
Feb 19 2018 by JEFFERSON R SOUSA, Tecg.º (Biomedical Systems Technology)
Patient female, 57 years old, with a low-vision complaint seven months ago. In specific ophthalmology exams, important changes were observed funducópicas suggestive of hemangioma de choroid.
Photographer: JEFFERSON R SOUSA - Study Center and Ophthalmological Research Dr. Andre M V Gomes, Institute Dr. Suel Abujamra São Paulo-Brazil
Condition/keywords: choroidal hemangioma
-
Retinal hyperplasia
Feb 19 2018 by JEFFERSON R SOUSA, Tecg.º (Biomedical Systems Technology)
Female patient, 28 years in monitoring to control a hyperpigmented lesion in the temporal retina of the right eye.
Photographer: Photographer JEFFERSON ROCHA DE SOUSA, Clinic Dr. Marco Antonio Albhy Oftalmology, Institute Dr. Suel Abujamra São Paulo-Brazil
Imaging device: Retinografo Topcin TRC-NW6S. Mosaic, Flash 25.
Condition/keywords: hyperplasia, hyperplastic retinal pigment epithelium (RPE)
-
Endophthalmitis
Feb 17 2018 by JEFFERSON R SOUSA, Tecg.º (Biomedical Systems Technology)
A 56-year-old male patient, with vision loss, with no light perception in the right eye, the presence of secretion in the anterior chamber was evaluated.
Photographer: JEFFERSON R SOUSA - Study Center and Ophthalmological Research Dr. Andre M V Gomes, Institute Dr. Suel Abujamra São Paulo-Brazil
Imaging device: Topcon TRC-50 DX, Imaginet 5.0, angle de 35 graus. Flash 36.
Condition/keywords: candida endophthalmitis, delayed onset endophthalmitis
-
 Endophthalmitis
Endophthalmitis
Feb 17 2018 by JEFFERSON R SOUSA, Tecg.º (Biomedical Systems Technology)
A 56-year-old male patient, with vision loss, with no light perception in the right eye, the presence of secretion in the anterior chamber was evaluated.
Photographer: JEFFERSON R SOUSA - Study Center and Ophthalmological Research Dr. Andre M V Gomes, Institute Dr. Suel Abujamra São Paulo-Brazil
Imaging device: Topcon TRC-50 DX, Imaginet 5.0, angle de 35 graus. Flash 36, image with digital zoom.
Condition/keywords: endophthalmitis
-
 Leber's Miliary Aneurysm
Leber's Miliary Aneurysm
Feb 17 2018 by JEFFERSON R SOUSA, Tecg.º (Biomedical Systems Technology)
Male patient, 29 years old, with low vision in the right eye has 9 months. In the retinal mapping and color retinography examination, there were important fundoscopical alterations.
Photographer: JEFFERSON R SOUSA - Study Center and Ophthalmological Research Dr. Andre M V Gomes, Institute Dr. Suel Abujamra São Paulo-Brazil
Imaging device: Fundus camera Topcon TRC-50 DX, Imaginet 5.0, angle de 50 graus. Flash 36 / Mosaic with 11 images.
Condition/keywords: Leber's miliary aneurysm, lipid exudation, massive lipid exudation
-
Hemangioma Coroideo
Hemangioma Coroideo
Feb 17 2018 by JEFFERSON R SOUSA, Tecg.º (Biomedical Systems Technology)
A 33-year-old patient complained of low vision in the left eye. In the retinal and retinal mapping examination, there were important fundoscopic alterations suggestive of choroidal hemangioma. Such alterations were confirmed in the Ocular Ultrasonography examination. And also in Optical Coherence Tomography.
Photographer: JEFFERSON R SOUSA - Study Center and Ophthalmological Research Dr. Andre M V Gomes, Institute Dr. Suel Abujamra São Paulo-Brazil
Imaging device: OCT CIRRUS 4000, Line Protocol, three line assembly.
Condition/keywords: choroidal hemangioma
-
 Retinal Detachment
Retinal Detachment
Feb 17 2018 by JEFFERSON R SOUSA, Tecg.º (Biomedical Systems Technology)
A 42-year-old patient complained of low vision in the left eye. In retinal mapping and background color photography, extensive retinal detachment was observed.
Photographer: JEFFERSON R SOUSA - Study Center and Ophthalmological Research Dr. Andre M V Gomes, Institute Dr. Suel Abujamra São Paulo-Brazil
Imaging device: Fundus camera Topcon TRC-50 DX, Imaginet 5.0, angle de 50 graus. Flash 36 / Mosaic with 10 images.
-
 Retinal Detachment
Retinal Detachment
Feb 8 2018 by JEFFERSON R SOUSA, Tecg.º (Biomedical Systems Technology)
The male patient attended the clinic with low vision. In the retinal and retinal mapping examination, important fudoscopical alterations were observed. Full retinal detachment with Giant rupture in upper temporal arch.
Photographer: JEFFERSON R SOUSA - Study Center and Ophthalmological Research Dr. Andre M V Gomes, Institute Dr. Suel Abujamra São Paulo-Brazil
Imaging device: Fundus camera Topcon TRC-50 DX, Imaginet 5.0, campo de 50 graus. Flash 36 / Mosaic with 16 images.
Condition/keywords: retinal in rupture
-
 Coloboma
Coloboma
Jan 23 2018 by JEFFERSON R SOUSA, Tecg.º (Biomedical Systems Technology)
Male patient, 22 years old, with low vision since infancy. In retinal and retinal mapping examinations, important alterations were observed in the formation of retinochoroidal structures suggestive of coloboma.
Photographer: JEFFERSON R SOUSA - Study Center and Ophthalmological Research Dr. Andre M V Gomes, Dr. Suel Abujamra Institute São Paulo-Brazil
Imaging device: Acquisition of the image in the Camera background Topcon TRC-50 Dx - IA, Keystone field photo of 50 Degrees. Composition automatic of Imaginet with manual adjustment
Condition/keywords: coloboma, coloboma of choroid
-
 Proliferative Diabetic Retinopathy
Proliferative Diabetic Retinopathy
Jan 23 2018 by JEFFERSON R SOUSA, Tecg.º (Biomedical Systems Technology)
Male patient, 16-years-old, with type II diabetes mellitus, 320 MD / DL mean of glycemic control of the last five months. He attended the clinic complaining of low vision of both eyes. In the fluorescent retinal examination, several extravasation points corresponding to retinal neovascularization (Proliferative Diabetic Retinopathy) were observed.
Photographer: JEFFERSON R SOUSA - Study Center and Ophthalmological Research Dr. Andre M V Gomes, Dr. Suel Abujamra Institute São Paulo-Brazil
Imaging device: Acquisition of the image in the Camera background Topcon TRC-50 Dx - IA, Keystone field photo of 50 Degrees. Composition automatic of Imaginet with manual adjustment.
Condition/keywords: proliferative diabetic retinopathy (PDR)
-
 Proliferative Diabetic Retinopathy
Proliferative Diabetic Retinopathy
Jan 23 2018 by JEFFERSON R SOUSA, Tecg.º (Biomedical Systems Technology)
Male patient, 16 years old, with type II diabetes mellitus, 320 MD / DL mean of glycemic control of the last five months. He attended the clinic complaining of low vision of both eyes. In the fluorescent retinal examination, several extravasation points corresponding to retinal neovascularization (proliferative diabetic retinopathy) were observed.
Photographer: JEFFERSON R SOUSA - Study Center and Ophthalmological Research Dr. Andre M V Gomes, Dr. Suel Abujamra Institute São Paulo-Brazil
Imaging device: Acquisition of the image in the Camera background Topcon TRC-50 Dx - IA, Keystone field photo of 50 Degrees. Composition automatic of Imaginet with manual adjustment.
Condition/keywords: proliferative diabetic retinopathy (PDR)
-
 valsalva retinopathy
valsalva retinopathy
Feb 6 2018 by JEFFERSON R SOUSA, Tecg.º (Biomedical Systems Technology)
A 28-year-old female patient, at the 28th week of gestation, presented low vision. Retinal mapping and retinography examination revealed extensive subhaloidal haemorrhage suggestive of RETINOPATHY VALSALVA in pregnancy. In periodic follow-up, spontaneous reabsorption of the hemorrhage was observed.
Photographer: JEFFERSON R SOUSA - Study Center and Ophthalmological Research Dr. Andre M V Gomes, Institute Dr. Suel Abujamra São Paulo-Brazil
Imaging device: Fundus camera Topcon TRC-50 DX, Imaginet, 50 degree field. Flash 50
Condition/keywords: valsalva retinopathy
-
 Choroidal Neovascular Membrane (CNVM)
Choroidal Neovascular Membrane (CNVM)
Jan 23 2018 by JEFFERSON R SOUSA, Tecg.º (Biomedical Systems Technology)
Female patient, 56 years old with low vision in the left eye on Fluorescent Retinography with Green Indocyanine showed a pattern of subretinal neovascular formation, typical of the subetinal neovascular membrane.
Photographer: JEFFERSON R SOUSA - Study Center and Ophthalmological Research Dr. Andre M V Gomes, Dr. Suel Abujamra Institute São Paulo-Brazil
Imaging device: Acquisition of the image in the Camera background Zeiss - Visucam-500.
Condition/keywords: choroidal neovascular membrane (CNVM)
-
Glaucoma
Feb 8 2018 by JEFFERSON R SOUSA, Tecg.º (Biomedical Systems Technology)
Male patient, 61-years-old in follow-up of glaucoma has several years. She performed trabeculectomy surgery with a tube implant.
Photographer: JEFFERSON R SOUSA - Study Center and Ophthalmological Research Dr. Andre M V Gomes, Dr. Suel Abujamra Institute São Paulo-Brazil
Imaging device: Fundus camera Acquisition of the image in the Camera background Topcon TRC-50 Dx - IA, field photo of 50 Degrees. Composition manual adjustment.
Condition/keywords: glaucoma
-
 Diabetic Retinopathy With Laser Photocoagulation.
Diabetic Retinopathy With Laser Photocoagulation.
Sep 10 2017 by JEFFERSON R SOUSA, Tecg.º (Biomedical Systems Technology)
Patient patient 55-year-old, female, attended the clinic with complaint of low visual acuity. It was subjected to laser photocoagulation.
Photographer: JEFFERSON R SOUSA - Study Center and Ophthalmological Research Dr. Andre M V Gomes, Dr. Suel Abujamra Institute São Paulo-Brazil
Imaging device: Topcon TRC-50 DX, Imaginet, 50 degree field. Flash 75, mosaic with eleven images.
Condition/keywords: background diabetic retinopathy (BDR)
-
 Diabetic Retinopathy With Laser Photocoagulation.
Diabetic Retinopathy With Laser Photocoagulation.
Sep 10 2017 by JEFFERSON R SOUSA, Tecg.º (Biomedical Systems Technology)
Patient atient 55-years-old, female, attended the clinic with complaint of low visual acuity. It was subjected to laser photocoagulation.
Photographer: JEFFERSON R SOUSA - Study Center and Ophthalmological Research Dr. Andre M V Gomes, Dr. Suel Abujamra Institute São Paulo-Brazil
Imaging device: Topcon TRC-50 DX, Imaginet, 50 degree field. Flash 75, mosaic with eleven images.
Condition/keywords: background diabetic retinopathy (BDR)
-
 Multiple Retinal Holes
Multiple Retinal Holes
Sep 10 2017 by JEFFERSON R SOUSA, Tecg.º (Biomedical Systems Technology)
Patient 57-years-old, male, attended the clinic with complaint of low visual acuity and history of already having undergone a surgical procedure in another service. In previous evaluation of retinal mapping and retinography, being confirmed in optical coherence tomography, several retinal holes were observed in the posterior pole.
Photographer: JEFFERSON R SOUSA - Study Center and Ophthalmological Research Dr. Andre M V Gomes, Dr. Suel Abujamra Institute São Paulo-Brazil
Imaging device: Retinografo Topcon TRC-50 DX, Imaginet, campo de 50 graus. Flash 75
Condition/keywords: retinal hole
-
 Multiple Retinal Holes
Multiple Retinal Holes
Sep 10 2017 by JEFFERSON R SOUSA, Tecg.º (Biomedical Systems Technology)
Patient 57-years-old, male, attended the clinic with complaint of low visual acuity and history of already having undergone a surgical procedure in another service. In previous evaluation of retinal mapping and retinography, being confirmed in optical coherence tomography, several retinal holes were observed in the posterior pole. Each arrow represents a hole. Nine retinal holes in the posterior pole
Photographer: JEFFERSON R SOUSA - Study Center and Ophthalmological Research Dr. Andre M V Gomes, Dr. Suel Abujamra Institute São Paulo-Brazil
Imaging device: Retinografo Topcon TRC-50 DX, Imaginet, campo de 50 graus. Flash 75
Condition/keywords: retinal hole
-
 Multiple Retinal Holes
Multiple Retinal Holes
Sep 10 2017 by JEFFERSON R SOUSA, Tecg.º (Biomedical Systems Technology)
Patient 57-years-old, male, attended the clinic with complaint of low visual acuity and history of already having undergone a surgical procedure in another service. In previous evaluation of retinal mapping and retinography, being confirmed in optical coherence tomography, several retinal holes were observed in the posterior pole.
Photographer: JEFFERSON R SOUSA - Study Center and Ophthalmological Research Dr. Andre M V Gomes, Dr. Suel Abujamra Institute São Paulo-Brazil
Imaging device: Topcon TRC-50 DX, Imaginet, campo de 50 graus. Flash 75 / Optical coherence tomography system OCT CIRRUS 4000, Protocol Line 125 degrees.
Condition/keywords: retinal hole
-
 Multiple Retinal Holes
Multiple Retinal Holes
Sep 10 2017 by JEFFERSON R SOUSA, Tecg.º (Biomedical Systems Technology)
Patient 57-years-old, male, attended the clinic with complaint of low visual acuity and history of already having undergone a surgical procedure in another service. In previous evaluation of retinal mapping and retinography, being confirmed in optical coherence tomography, several retinal holes were observed in the posterior pole.
Photographer: JEFFERSON R SOUSA - Study Center and Ophthalmological Research Dr. Andre M V Gomes, Dr. Suel Abujamra Institute São Paulo-Brazil
Imaging device: OCT CIRRUS 4000, Protocol Horizontal line.
Condition/keywords: retinal hole
-
 Multiple Retinal Holes
Multiple Retinal Holes
Sep 10 2017 by JEFFERSON R SOUSA, Tecg.º (Biomedical Systems Technology)
Patient 57-years-old, male, attended the clinic with complaint of low visual acuity and history of already having undergone a surgical procedure in another service. In previous evaluation of retinal mapping and retinography, being confirmed in optical coherence tomography, several retinal holes were observed in the posterior pole.
Photographer: JEFFERSON R SOUSA - Study Center and Ophthalmological Research Dr. Andre M V Gomes, Dr. Suel Abujamra Institute São Paulo-Brazil
Imaging device: OCT CIRRUS 4000, Protocol Horizontal line.
Condition/keywords: retinal hole
-
 Multiple Retinal Holes
Multiple Retinal Holes
Sep 10 2017 by JEFFERSON R SOUSA, Tecg.º (Biomedical Systems Technology)
Patient 57-years-old, male, attended the clinic with complaint of low visual acuity and history of already having undergone a surgical procedure in another service. In previous evaluation of retinal mapping and retinography, being confirmed in optical coherence tomography, several retinal holes were observed in the posterior pole.
Photographer: JEFFERSON R SOUSA - Study Center and Ophthalmological Research Dr. Andre M V Gomes, Dr. Suel Abujamra Institute São Paulo-Brazil
Imaging device: OCT CIRRUS 4000, Protocol Line, transverse 125 degrees.
Condition/keywords: retinal hole
-
 Multiple Retinal Holes
Multiple Retinal Holes
Sep 10 2017 by JEFFERSON R SOUSA, Tecg.º (Biomedical Systems Technology)
Patient 57-years-old, male, attended the clinic with complaint of low visual acuity and history of already having undergone a surgical procedure in another service. In previous evaluation of retinal mapping and retinography, being confirmed in optical coherence tomography, several retinal holes were observed in the posterior pole.
Photographer: JEFFERSON R SOUSA - Study Center and Ophthalmological Research Dr. Andre M V Gomes, Dr. Suel Abujamra Institute São Paulo-Brazil
Imaging device: OCT CIRRUS 4000, Protocol Horizontal line.
Condition/keywords: retinal hole
-
 Macular Vitreotraction
Macular Vitreotraction
Aug 25 2017 by JEFFERSON R SOUSA, Tecg.º (Biomedical Systems Technology)
A 56-year-old female patient had a low vision clinic, a vitreoretinal traction was observed on the OCT examination.
Photographer: JEFFERSON R SOUSA - Study Center and Ophthalmological Research Dr. Andre M V Gomes, Dr. Suel Abujamra Institute São Paulo-Brazil
Imaging device: OCT CIRRUS 4000, Protocol Line 6mm, 90 degrees.
Condition/keywords: macular traction
-
Macular Vitreotraction
Macular Vitreotraction
Aug 25 2017 by JEFFERSON R SOUSA, Tecg.º (Biomedical Systems Technology)
A 56-year-old female patient had a low vision clinic, a vitreoretinal traction was observed on the OCT examination.
Photographer: JEFFERSON R SOUSA - Study Center and Ophthalmological Research Dr. Andre M V Gomes, Dr. Suel Abujamra Institute São Paulo-Brazil
Imaging device: OCT CIRRUS 4000, Protocol Line 6mm, 90 degrees.
Condition/keywords: macular traction
-
 Macular Vitreotraction
Macular Vitreotraction
Aug 25 2017 by JEFFERSON R SOUSA, Tecg.º (Biomedical Systems Technology)
A 56-year-old female patient had a low vision clinic, a vitreoretinal traction was observed on the OCT examination.
Photographer: JEFFERSON R SOUSA - Study Center and Ophthalmological Research Dr. Andre M V Gomes, Dr. Suel Abujamra Institute São Paulo-Brazil
Imaging device: OCT CIRRUS 4000, Protocol Line 6mm, 90 degrees.
Condition/keywords: macular traction
-
 Gyrus Dystrophy
Gyrus Dystrophy
Aug 24 2017 by JEFFERSON R SOUSA, Tecg.º (Biomedical Systems Technology)
A 53-year-old female patient, attended the clinic complaining of low vision. In the retinal mapping and retinography examination, we observed important atrophic alterations in the extreme periphery of the eyes as well as the posterior pole. AV AO 20/100 S/C
Photographer: JEFFERSON R SOUSA - Study Center and Ophthalmological Research Dr. Andre M V Gomes, Dr. Suel Abujamra Institute São Paulo-Brazil
Imaging device: Topcon TRC-50 DX, Imaginet, 50 degree field. Flash 50 / Mosaic with 16 images.
Condition/keywords: gyrus dystrophy
-
 Gyrus Dystrophy
Gyrus Dystrophy
Aug 24 2017 by JEFFERSON R SOUSA, Tecg.º (Biomedical Systems Technology)
A 53-year-old female patient, attended the clinic complaining of low vision. In the retinal mapping and retinography examination, we observed important atrophic alterations in the extreme periphery of the eyes as well as the posterior pole. AV AO 20/100 S/C
Photographer: JEFFERSON R SOUSA - Study Center and Ophthalmological Research Dr. Andre M V Gomes, Dr. Suel Abujamra Institute São Paulo-Brazil
Condition/keywords: gyrus dystrophy
-
 Disease of Eales
Disease of Eales
Aug 24 2017 by JEFFERSON R SOUSA, Tecg.º (Biomedical Systems Technology)
A 23-year-old male, Caucasian, attended the clinic with a complaint of progressive loss of vision. In the retinal mapping and retinography examination, we observed important alterations that suggested inflammatory processes. However, it turned negative for all laboratory tests.
Photographer: JEFFERSON R SOUSA - Study Center and Ophthalmological Research Dr. Andre M V Gomes, Institute Dr. Suel Abujamra São Paulo-Brazil
Imaging device: Topcon TRC-50 DX, Imaginet, campo de 50 graus. Flash 75 / Mosaic with 16 images.
Condition/keywords: Eales disease
-
 Disease of Eales
Disease of Eales
Aug 24 2017 by JEFFERSON R SOUSA, Tecg.º (Biomedical Systems Technology)
A 23-year-old male, Caucasian, attended the clinic with a complaint of progressive loss of vision. In the retinal mapping and retinography examination, we observed important alterations that suggested inflammatory processes. However, it turned negative for all laboratory tests.
Photographer: JEFFERSON R SOUSA - Study Center and Ophthalmological Research Dr. Andre M V Gomes, Institute Dr. Suel Abujamra São Paulo-Brazil
Imaging device: Topcon TRC-50 DX, Imaginet, campo de 50 graus. Flash 75 / Mosaic with 16 images.
Condition/keywords: Eales disease
-
 Macroaneurysms
Macroaneurysms
Jul 7 2017 by JEFFERSON R SOUSA, Tecg.º (Biomedical Systems Technology)
55-year-old Asian female patient. In routine consultation was made retinography for documentation where he observed presence of macroaneurysm in the middle inferior periphery.
Photographer: JEFFERSON R SOUSA - Suel Abujamra Institute - São Paulo - Brazil
Imaging device: Topcon TRC-50Dx. 20 degree angle with digital magnification, flash in 75. Oct A-SOCT Copernicus Revo/Optopol. 3mm. Digital magnification.
Condition/keywords: macroaneurysm
-
 Allergic Reaction
Allergic Reaction
Jan 26 2017 by JEFFERSON R SOUSA, Tecg.º (Biomedical Systems Technology)
Male patient, 25-years-old, presented an allergic reaction to the contrast of sodium fluorescein angiographic during the procedure. In the first minute after intravenous injection of contrast, noticed some rashes on the face, hyperfluorescent and evolution of edema of eyelids and lower lip.
Photographer: JEFFERSON R SOUSA
Imaging device: Topcon TRC-50 Dx IA - Angulation of field photo of 35 Degrees, flash 36, Digital system Imaginet
Condition/keywords: allergic reaction
-
 Retinopathy Valsalva
Retinopathy Valsalva
Jan 26 2017 by JEFFERSON R SOUSA, Tecg.º (Biomedical Systems Technology)
Male patient, 23-year-old, with low visual acuity in the right eye. In the ocular examination of the retinography, intense sub hyaloidal hemorrhage.
Photographer: JEFFERSON R SOUSA
Imaging device: Retinografo Topcon TRC-50 DX, Imaginet, campo de 35 graus. Flash 36
Condition/keywords: valsalva retinopathy
-
 Valsalva Retinopathy
Valsalva Retinopathy
Jan 26 2017 by JEFFERSON R SOUSA, Tecg.º (Biomedical Systems Technology)
Male patient, 23-years-old, with low visual acuity in the right eye. In the ocular examination of the retinography, intense subhyaloidal hemorrhage. 1 minute after laser application.
Photographer: JEFFERSON R SOUSA - Study Center and Ophthalmological Research Dr. Andre M V Gomes, Institute Dr. Suel Abujamra São Paulo-Brazil
Imaging device: Topcon TRC-50 DX, Imaginet, campo de 35 graus. Flash 36 / Mosaic with three images.
Condition/keywords: valsalva retinopathy
-
Valsalva Retinopathy
Jan 26 2017 by JEFFERSON R SOUSA, Tecg.º (Biomedical Systems Technology)
Male patient, 23-years-old, with low visual acuity in the right eye. In the ocular examination of the retinography, intense subhyaloidal hemorrhage. 2 minutes after laser application.
Photographer: JEFFERSON R SOUSA - Suel Abujamra Institute - São Paulo - Brazil
Imaging device: Topcon TRC-50 DX, Imaginet, 35 degree field. Flash 36 / Mosaic with four images.
Condition/keywords: subhyaloid hemorrhage, valsalva retinopathy
-
 Papilledema
Papilledema
Nov 21 2016 by JEFFERSON R SOUSA, Tecg.º (Biomedical Systems Technology)
Patient female, 51-year-old, white. attended the clinic with the complaint of low vision, flash, right in the eye and headaches. In the examination of the fundus of the eye were observed important changes such as the Papilledema unilateral. Just confirmation more detailed examination angiographic.
Photographer: JEFFERSON R SOUSA - Study Center and Ophthalmological Research Dr. Andre M V Gomes, Institute Dr. Suel Abujamra São Paulo-Brazil
Imaging device: Topcon TRC-50 Ex - Angulation of field photo of 35 Degrees. Digital system OphthaVision
Condition/keywords: papilledema
-
Pigment Epithelial Detachment
Nov 20 2016 by JEFFERSON R SOUSA, Tecg.º (Biomedical Systems Technology)
Female patient, 43-years-old, Caucasian. Attended the clinic with complaint of low vision. In the fundus evaluation, DEP was observed in the upper region with macular involvement.
Photographer: JEFFERSON R SOUSA - Study Center and Ophthalmological Research Dr. Andre M V Gomes, Institute Dr. Suel Abujamra São Paulo-Brazil
Imaging device: OCT Cirrus - Zeiss / Cut in line from 11 to 5hr.
Condition/keywords: large pigment epithelial detachment, pigment epithelial detachment (PED)
-
 Degeneration Paravenous
Degeneration Paravenous
Sep 20 2016 by JEFFERSON R SOUSA, Tecg.º (Biomedical Systems Technology)
Female patient, 32-years-old, Asian, appeared at the clinic with a history of glaucoma. 20/20 Visual acuity in both eyes. Examination of color photography, pigmentary changes were observed following the vascular arcades only in the left eye. Suggestive of paravenous degeneration.
Photographer: JEFFERSON R SOUSA - Study Center and Ophthalmological Research Dr. Andre M V Gomes, Institute Dr. Suel Abujamra São Paulo-Brazil
Imaging device: Zeiss / VisuCam-500 - Angulation of field photo of 45 Degrees, flash 11.
Condition/keywords: degeneration paravenous
-
 Degeneration Paravenous
Degeneration Paravenous
Sep 20 2016 by JEFFERSON R SOUSA, Tecg.º (Biomedical Systems Technology)
Female patient, 32-years-old, Asian, appeared at the clinic with a history of glaucoma. 20/20 visual acuity in both eyes. Examination of color photography, pigmentary changes were observed following the vascular arcades only in the left eye. Suggestive of paravenous degeneration.
Photographer: JEFFERSON R SOUSA - Study Center and Ophthalmological Research Dr. Andre M V Gomes, Institute Dr. Suel Abujamra São Paulo-Brazil
Imaging device: Zeiss / VisuCam-500 - Angulation of field photo of 45 Degrees, flash 11.
Condition/keywords: degeneration paravenous
-
 Degeneration Paravenous
Degeneration Paravenous
Sep 20 2016 by JEFFERSON R SOUSA, Tecg.º (Biomedical Systems Technology)
Female patient, 32-years-old, Asian, appeared at the clinic with a history of glaucoma. 20/20 visual acuity in both eyes. Examination of color photography, pigmentary changes were observed following the vascular arcades only in the left eye. Suggestive of paravenous degeneration.
Photographer: JEFFERSON R SOUSA - Study Center and Ophthalmological Research Dr. Andre M V Gomes, Institute Dr. Suel Abujamra São Paulo-Brazil
Imaging device: Zeiss / VisuCam-500 - Angulation of field photo of 45 Degrees, flash 24.
Condition/keywords: degeneration paravenous
-
 Degeneration Paravenous
Degeneration Paravenous
Sep 20 2016 by JEFFERSON R SOUSA, Tecg.º (Biomedical Systems Technology)
Female patient, 32-years-old, Asian, appeared at the clinic with a history of glaucoma. 20/20 visual acuity in both eyes. Examination of color photography, pigmentary changes were observed following the vascular arcades only in the left eye. Suggestive of paravenous degeneration.
Photographer: JEFFERSON R SOUSA - Study Center and Ophthalmological Research Dr. Andre M V Gomes, Institute Dr. Suel Abujamra São Paulo-Brazil
Imaging device: Zeiss / VisuCam-500 - Angulation of field photo of 45 Degrees, flash 17.
Condition/keywords: degeneration paravenous
-
 Coats' Disease
Coats' Disease
Sep 13 2016 by JEFFERSON R SOUSA, Tecg.º (Biomedical Systems Technology)
Patient male, 30-years-old, with complaint of slight difficulty in vision in his left eye. Absence of systemic diseases. He only has a history of glaucoma in the family.
Photographer: JEFFERSON R SOUSA - Study Center and Ophthalmological Research Dr. Andre M V Gomes, Institute Dr. Suel Abujamra São Paulo-Brazil
Imaging device: Zeiss / VisuCam-500 - Angulation of field photo of 45 Degrees, flash 14 color end 24 Fundus Angiografy, digital magnification 6x
Condition/keywords: Coats' disease
-
 Age-Related Macular Degeneration
Age-Related Macular Degeneration
Sep 12 2016 by JEFFERSON R SOUSA, Tecg.º (Biomedical Systems Technology)
Female patient, 57-years-old complaining of low vision, image with tortuosity in both eyes.
Photographer: JEFFERSON R SOUSA - Study Center and Ophthalmological Research Dr. Andre M V Gomes, Institute Dr. Suel Abujamra São Paulo-Brazil
Imaging device: OCT-Cirrus, HD 5 online with 3D cube. Color photography with Topcon TRC-50 Ex/OphthaVision
Condition/keywords: age-related macular degeneration (AMD)
-
 Age-Related Macular Degeneration
Age-Related Macular Degeneration
Sep 12 2016 by JEFFERSON R SOUSA, Tecg.º (Biomedical Systems Technology)
Female patient, 57-years-old complaining of low vision, image with tortuosity in both eyes.
Photographer: JEFFERSON R SOUSA - Study Center and Ophthalmological Research Dr. Andre M V Gomes, Institute Dr. Suel Abujamra São Paulo-Brazil
Imaging device: OCT-Cirrus, HD 5 online with 3D cube. Color photography with Topcon TRC-50 Ex/OphthaVision
Condition/keywords: age-related macular degeneration (AMD)
-
 Cavernous Hemangioma of the Retina
Cavernous Hemangioma of the Retina
Sep 11 2016 by JEFFERSON R SOUSA, Tecg.º (Biomedical Systems Technology)
A female patient, 13 years of age, with complaint of low vision in her left eye, had esotropia in this eye. In the examination of fundoscopy and color photograph, we observed a pattern of multiple formations venous aneurysm with aspects of bunches of grapes in the nasal cavity above, which is characteristic of the cavernous hemangiomas of the retina.
Photographer: JEFFERSON R SOUSA - Study Center and Ophthalmological Research Dr. Andre M V Gomes, Institute Dr. Suel Abujamra São Paulo-Brazil
Imaging device: Topcon TRC-50VT, Film, Kodak Ektachrome 160 - ASA 100 / 35mm, field of 35 degrees. Flash 100.
Condition/keywords: cavernous hemangioma of the retina, tumor
-
 Cysticercosis
Cysticercosis
Jan 26 2017 by JEFFERSON R SOUSA, Tecg.º (Biomedical Systems Technology)
Female patient, 20-year-old, visual acuity (PL) luminous perception in the right eye. In the ocular examination of the retinography, intense opacity and presence of a cysticercosis.
Photographer: JEFFERSON R SOUSA - Study Center and Ophthalmological Research Dr. Andre M V Gomes, Institute Dr. Suel Abujamra São Paulo-Brazil
Imaging device: Topcon TRC- VT - Angulation of field photo of 35 Degrees.
Condition/keywords: cyst, cysticercosis
-
 Cavernous Hemangioma of the Retina
Cavernous Hemangioma of the Retina
Sep 11 2016 by JEFFERSON R SOUSA, Tecg.º (Biomedical Systems Technology)
Male patient, 46-years-old, complaining of loss of the nasal field. In the examination of fluorescent angiography showed a pattern of hiperfluorescência and hipofluorescência typical of cavernous hemangioma.
Photographer: JEFFERSON R SOUSA - Study Center and Ophthalmological Research Dr. Andre M V Gomes, Institute Dr. Suel Abujamra São Paulo-Brazil
Imaging device: Zeiss / VisuCam-500 - Angulation of field photo of 45 Degrees, flash 24, digital magnification 4x
Condition/keywords: cavernous hemangioma of papilla, cavernous hemangioma of the retina, tumor
-
 Cavernous Hemangioma of Papilla
Cavernous Hemangioma of Papilla
Sep 11 2016 by JEFFERSON R SOUSA, Tecg.º (Biomedical Systems Technology)
Male patient, 46-years-old, complaining of loss of the nasal field. The funduscopy revealed important vascular changes with aspects of bunch of grapes above-papillae.
Photographer: JEFFERSON R SOUSA - Study Center and Ophthalmological Research Dr. Andre M V Gomes, Institute Dr. Suel Abujamra São Paulo-Brazil
Imaging device: Zeiss / VisuCam-500 - Angulation of field photo of 45 Degrees, flash 16, digital magnification 4x
Condition/keywords: cavernous hemangioma of papilla, cavernous hemangioma of the retina, tumor
-
 Papilloma Conjunctiva
Papilloma Conjunctiva
Sep 2 2016 by JEFFERSON R SOUSA, Tecg.º (Biomedical Systems Technology)
Female patient, 26-years-old without complaint of ocular symptoms, only the of spot avermelha in the right eye. Absence of changes in positions of the look. Intraocular pressure visual acuity and fundoscopy without changes.
Photographer: JEFFERSON R SOUSA - Study Center and Ophthalmological Research Dr. Andre M V Gomes, Institute Dr. Suel Abujamra São Paulo-Brazil
Imaging device: Topcon TRC-50 Dx - Angulation of field photo of 35 Degrees, flash 36, Digital system Imaginet
Condition/keywords: conjunctival cysts, papilloma, papilloma conjunctiva, tumor
-
 DUSN (Diffuse Unilateral Subacute Neuroretinitis)
DUSN (Diffuse Unilateral Subacute Neuroretinitis)
Sep 2 2016 by JEFFERSON R SOUSA, Tecg.º (Biomedical Systems Technology)
Patient female, 15-year-old, he entered the clinic with complaint of low vision, visual acuity without correction was 20/60 in the right eye and 20/30 in the left eye. In the ocular exam of retinografia, there was change in the epithelium macular pigment and a small larva juxtafoveal above.
Photographer: JEFFERSON R SOUSA - Study Center and Ophthalmological Research Dr. Andre M V Gomes, Institute Dr. Suel Abujamra São Paulo-Brazil
Imaging device: Topcon TRC-50 Dx - Angulation of field photo of 35 Degrees, flash 36, Digital system Imaginet
Condition/keywords: diffuse unilateral subacute neuroretinitis (DUSN), larva, uveitis
-
 DUSN (Diffuse Unilateral Subacute Neuroretinitis)
DUSN (Diffuse Unilateral Subacute Neuroretinitis)
Sep 2 2016 by JEFFERSON R SOUSA, Tecg.º (Biomedical Systems Technology)
Patient female, 15-year-old, he entered the clinic with complaint of low vision, visual acuity without correction was 20/60 in the right eye and 20/30 in the left eye. In the ocular exam of retinografia, there was change in the epithelium macular pigment and a small larva juxtafoveal above.
Photographer: JEFFERSON R SOUSA - Study Center and Ophthalmological Research Dr. Andre M V Gomes, Institute Dr. Suel Abujamra São Paulo-Brazil
Imaging device: Topcon TRC-50 Dx - Angulation of field photo of 35 Degrees, flash 36, Digital system Imaginet
Condition/keywords: diffuse unilateral subacute neuroretinitis (DUSN), larva, uveitis
-
 DUSN (Diffuse Unilateral Subacute Neuroretinitis)
DUSN (Diffuse Unilateral Subacute Neuroretinitis)
Sep 2 2016 by JEFFERSON R SOUSA, Tecg.º (Biomedical Systems Technology)
Patient female, 15-year-old, he entered the clinic with complaint of low vision, visual acuity without correction was 20/60 in the right eye and 20/30 in the left eye. In the ocular exam of retinografia, there was change in the epithelium macular pigment and a small larva juxtafoveal above.
Photographer: JEFFERSON R SOUSA - Study Center and Ophthalmological Research Dr. Andre M V Gomes, Institute Dr. Suel Abujamra São Paulo-Brazil
Imaging device: Topcon TRC-50 Dx - Angulation of field photo of 20 Degrees, flash 36, Digital system Imaginet
Condition/keywords: diffuse unilateral subacute neuroretinitis (DUSN), larva, uveitis
-
 DUSN (Diffuse Unilateral Subacute Neuroretinitis)
DUSN (Diffuse Unilateral Subacute Neuroretinitis)
Sep 2 2016 by JEFFERSON R SOUSA, Tecg.º (Biomedical Systems Technology)
Patient female, 15-year-old, he entered the clinic with complaint of low vision, visual acuity without correction was 20/60 in the right eye and 20/30 in the left eye. In the ocular exam of retinografia, there was change in the epithelium macular pigment and a small larva juxtafoveal above.
Photographer: JEFFERSON R SOUSA - Study Center and Ophthalmological Research Dr. Andre M V Gomes, Institute Dr. Suel Abujamra São Paulo-Brazil
Imaging device: Topcon TRC-50 Dx - Angulation of field photo of 35 Degrees, filter Red Free, flash 75 system 75, Digital Imaginet
Condition/keywords: diffuse unilateral subacute neuroretinitis (DUSN), larva, uveitis
-
 Telangiectasia
Telangiectasia
Sep 1 2016 by JEFFERSON R SOUSA, Tecg.º (Biomedical Systems Technology)
Female patient, 33-years-old, visual acuity 20/60 uncorrected in both eyes.
Photographer: JEFFERSON R SOUSA - Intituto Suel Abujamra - São Paulo - Brasil
Imaging device: Topcon TRC-50 Ex - Angulation of field photo of 35 Degrees. Digital system OphthaVision
Condition/keywords: juxtafoveal telangiectasis, perifoveal telangiectasia
-
 Retinal Hemorrhage
Retinal Hemorrhage
Aug 31 2016 by JEFFERSON R SOUSA, Tecg.º (Biomedical Systems Technology)
Female patient, 50-years-old, suffered head trauma (blow), two days. After had low vision sudden in the left eye. Retinal evaluation does not show signs of peripheral retinal detachment.
Photographer: Jefferson R Sousa - Institute Dr. Suel Abujamra (ISA)/São Paulo-Brazil
Imaging device: TOPCON TRC-50DX/Imaginet System-Cam D7000, 36 Flash, Optical Angle of 50 and 35 degrees.
Condition/keywords: optic disc hemorrhage, retinal hemorrhage, subretinal hemorrhage
-
 Silicon Oil
Silicon Oil
Aug 29 2016 by JEFFERSON R SOUSA, Tecg.º (Biomedical Systems Technology)
Patient male, diabetic, hypertensive, was submitted to procedure surgical implant of silicone oil in which the formed bubbles.
Photographer: JEFFERSON R SOUSA - Institute Dr. Suel Abujamra / São Paulo - Brazil
Imaging device: Topcon TRC-50 Ex - Angulation of field photo of 35 Degrees. Digital system OphthaVision
Condition/keywords: silicone oil
-
 Macroaneurism
Macroaneurism
Aug 29 2016 by JEFFERSON R SOUSA, Tecg.º (Biomedical Systems Technology)
Patient female, 55-years-old, the bearer of hypertension, blood systemic and diabetes. Visual acuity 20/60 c/c. ja with the treatment of laser photocoagulation.
Photographer: JEFFERSON R SOUSA - Institute Dr. Suel Abujamra / São Paulo - Brazil
Imaging device: Topcon TRC-50 Ex - Angulation of field photo of 35 Degrees. Digital system OphthaVision
Condition/keywords: hypertension, macroaneurysm
-
 Dystrophy Best (Dystrophy, Macular Viteliforme)
Dystrophy Best (Dystrophy, Macular Viteliforme)
Aug 29 2016 by JEFFERSON R SOUSA, Tecg.º (Biomedical Systems Technology)
Patient Male, 23-years-old, refers to progressive decrease of vision since the age of 17. Visual acuity 20/60 - C/C in both eyes. Three members of the same family has the diagnosis of Best.
Photographer: JEFFERSON R SOUSA - Institute Dr. Suel Abujamra / São Paulo - Brazil
Imaging device: Topcon TRC-50VT, Adaptation Nikon Capture / Cam - D300 setup manual - ISO 300 / Mask is modified, the field of 35 degrees. Flash 75.
Condition/keywords: Best disease
-
Arterial Occlusion With Preservation of Cilioretinal Network
Aug 29 2016 by JEFFERSON R SOUSA, Tecg.º (Biomedical Systems Technology)
Patient male, 52-years-old, denies hypertension, blood systemic, and diabetes. Refers low subtle of vision, field loss and stain central.
Photographer: JEFFERSON R SOUSA - Institute Dr. Suel Abujamra / São Paulo - Brazil
Imaging device: Acquisition of the image in the Camera background Topcon TRC-50 Dx - IA, Keystone field photo of 50 Degrees. Composition automatic of Imaginet with manual adjustment.
Condition/keywords: arterial occlusion, hypertension
-
 LIO Dipped in the Vitreo
LIO Dipped in the Vitreo
Aug 29 2016 by JEFFERSON R SOUSA, Tecg.º (Biomedical Systems Technology)
Patient Male, 51-years-old, with treatment with laser photocoagulation in myopic degeneration peripheral. Did FEC. suffered trauma (elbow) and had LIO dipped in the víteo.
Photographer: JEFFERSON R SOUSA - Institute Dr. Suel Abujamra / São Paulo - Brazil
Imaging device: Topcon TRC-50VT, Film, Kodak Ektachrome 160 - ASA 100 / 35mm, field of 35 degrees. Flash 100.
Condition/keywords: lens, myopic degeneration
-
 Lens Luxation
Lens Luxation
Aug 29 2016 by JEFFERSON R SOUSA, Tecg.º (Biomedical Systems Technology)
Patient, 65-years-old, male, suffered trauma blunt (the jackpot) in the right eye. Ultrasound of the eye found dislocation the total of the crystalline.
Photographer: JEFFERSON R SOUSA - Institute Dr. Suel Abujamra / São Paulo - Brazil
Imaging device: Topcon TRC-50VT, Film Kodak Ektachrome 160 - ASA 100 / 35mm, field of 35 degrees. Flash 100.
Condition/keywords: dislocated lens, lens luxation
-
 Retinal detachment with Rupture Giant
Retinal detachment with Rupture Giant
Aug 29 2016 by JEFFERSON R SOUSA, Tecg.º (Biomedical Systems Technology)
Patient female, 28-years-old, low subtle vision after exercises weight. Holder of 8 degrees of myopia and already with a history of degeneration myopia peripheral in both eyes.
Photographer: JEFFERSON R SOUSA - Institute Dr. Suel Abujamra / São Paulo - Brazil
Imaging device: Camera Background Topcon TRC-50 Dx - IA, keystone field photographic 35 Degrees. Composition automatic Imaginet with manual adjustment.
Condition/keywords: bullous retinal detachment, detachment, rupture

A project from the American Society of Retina Specialists